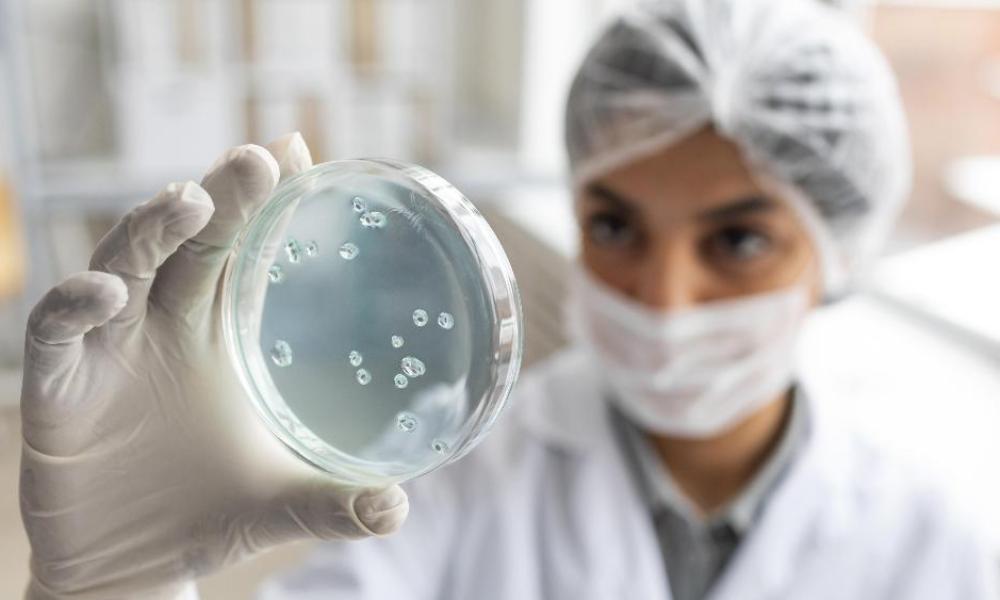
Китайские учёные обнаружили 8 новых вирусов и планируют с ними экспериментировать

Китайские учёные обнаружили 8 новых вирусов и планируют с ними экспериментировать
Они взяли пробы у крыс на острове Хайнань.
Известно, что один из вирусов принадлежит к тому же семейству, что и коронавирус. Также учёные выяснили, что обнаруженные патогены имеют «повышенную вероятность» заражения людей. Это может произойти в том случае, если они когда-либо преодолеют видовой барьер.Отметим, чтобы выявить уровень угрозы и узнать подробнее о вирусах, учёные намерены проводить с ними эксперименты.
Фото: freepik.com.
По теме:
В омском Роспотребнадзоре рассказали о заболеваемости ОРВИРоссийские медики предупредили о тройной эпидемии вирусов в этом сезоне
Теги
Поделиться новостью
Новости партнеров
По теме

